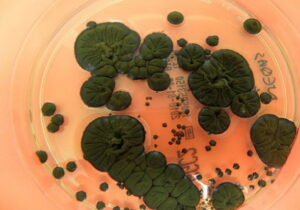
قارچ مرموز در تشعشعات هسته ای چرنوبیل زنده ماند
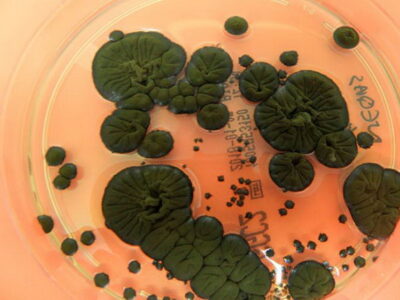
قارچ مرموز در تشعشعات هسته ای چرنوبیل زنده ماند

به گزارش تیکنا، تحولات فناوری در آستانه سال ۲۰۲۶ وارد مرحلهای پرشتاب شده است و رهبران فناوری با محیطی روبهرو هستند که در آن هوش مصنوعی دیگر یک گزینه نیست بلکه بنیان اصلی رقابت، امنیت و تابآوری سازمانی به شمار میرود. شدت این دگرگونی به حدی است که بسیاری از سازمانها ناگزیر هستند ساختارهای عملیاتی، مدلهای کسبوکار و معماری اطلاعاتی خود را بازتعریف کنند تا بتوانند از فرصتهای ناشی از توسعه هوش مصنوعی بهرهبرداری کنند و همزمان در برابر ریسکهای ناشی از آن نیز مصونیت ایجاد نمایند.
در این میان، گزارش گارتنر با معرفی ده روند راهبردی، تصویری گسترده و چندلایه از نقشه تحول فناوری ارائه و نشان میدهد که چگونه سازمانها باید زیرساختهای هوشمند ایجاد کنند، سامانههای چندعاملی را به کار گیرند و سازوکارهای حکمرانی و امنیت را برای عصر جدید بازطراحی کنند. بر همین اساس، ده روند برتر فناوری مؤسسه گارتنر برای سال ۲۰۲۶ به شرح زیر است.
- سکوهای توسعه بومی هوش مصنوعی (AI-native development platforms)
- سکوهای ابررایانش هوش مصنوعی (AI supercomputing platforms)
- رایانش محرمانه (Confidential computing)
- سامانههای چندعاملی (Multiagent systems)
- مدلهای زبانی تخصصی (Domain-specific language models)
- هوش مصنوعی فیزیکی (Physical AI)
- امنیت سایبری پیشدستانه (Preemptive cybersecurity)
- منشأ دیجیتال (Digital provenance)
- سکوهای امنیت هوش مصنوعی (AI security platforms)
- ژئوپاتریاسیون (Geopatriation)
این گزارش همچنین روشن میکند که این روندها نه صرفاً نوآوریهای فناورانه بلکه ابزارهایی راهبردی برای هدایت تصمیمگیری، کاهش پیچیدگی و ارتقای توان رقابتی در ساختارهای در حال تحول جهانی هستند. این نوشتار کوتاه بر پایه محتوای گزارش، منطق درونی این روندها را تفسیر میکند و پیامدهای راهبردی آنها را برای کسبوکارها تشریح میکند تا تصویر دقیقتری از این گذار فناورانه و چگونگی بهرهبرداری از آن فراهم شود.
معماری هوشمند برای عصر هوش مصنوعی
محور نخست گزارش گارتنر با عنوان «معمار» بر ایجاد زیرساختهایی متمرکز است که بتوانند فشار محاسباتی، پیچیدگی معماری و الزامات امنیتی عصر هوش مصنوعی را تاب بیاورند و زمینه تحول پایدار را فراهم کنند. در این محور، پلتفرمهای توسعه بومی هوش مصنوعی به عنوان نخستین روند کلیدی نقشی اساسی در بازآفرینی چرخه تولید نرمافزار ایفا میکنند؛ زیرا ادغام مستقیم مولدهای هوش مصنوعی در جریان طراحی، کدنویسی و آزمون امکان میدهد که تیمهای کوچک و چابک، محصولات پیشرفته را با سرعتی بسیار بیشتر از روشهای سنتی تولید کنند و از اتکا به ابزارهای خطی و زمانبر فاصله بگیرند. این روند موجب میشود ظرفیت تولید نرمافزار نه تنها افزایش یابد، بلکه الگوی توسعه به سمت فرایندهای سازگار با یادگیری مستمر، شخصیسازی و تولید مبتنی بر داده حرکت کند و سازمانها بتوانند در رقابت مبتنی بر سرعت امروز جایگاه بهتری کسب کنند.
در ادامه، پلتفرمهای ابررایانشی هوش مصنوعی به عنوان دومین روند راهبردی ظرفیت بیسابقهای برای آموزش مدلهای بزرگ، تحلیل داده و اجرای بارهای محاسباتی سنگین فراهم میکنند و امکان توسعه معماریهای عظیم مقیاس را برای سازمانها فراهم میسازند، هرچند هزینه تجهیز این سامانهها و پیچیدگی حاکمیت داده همچنان از چالشهای مهم باقی مانده است. روند سوم یعنی محاسبات محرمانه نیز چارچوبی ایجاد میکند که در آن داده حتی در زمان پردازش نیز در برابر دسترسیهای ناخواسته محافظت میشود و این ویژگی امکان تحلیلهای پیشرفته را در محیطهای ابری غیر قابل اعتماد به شیوهای ایمن ممکن میسازد و اعتمادپذیری فرایندهای محاسباتی را به شکل قابل توجهی افزایش میدهد.
سنتز مدلهای هوشمند و سامانههای چندعاملی
در محور «سنتز» که گارتنر آن را بنیان ارزشآفرینی مبتنی بر ترکیب مدلها و عاملهای هوشمند میداند و از آن به عنوان لایه تحولبخش میان زیرساخت و تجربه عملیاتی یاد میکند، سه روند اصلی معرفی شده است که هر یک جایگاه ویژهای در نقشه آینده فناوری دارند و در کنار یکدیگر ظرفیت ایجاد اکوسیستمی هماهنگ را فراهم میکنند.
بر همین اساس، سامانههای چندعاملی به عنوان چهارمین روند کلیدی نقشی اساسی در ایجاد ساختارهای خودکار برعهده دارند. تقسیم وظایف میان عاملهای هوشمند، مدیریت توزیعشده بار کاری و هماهنگی مستمر میان این عاملها امکان میدهد فعالیتهایی که پیش از این نیازمند مداخله انسانی بودند به صورت خودکار، سریع و در مقیاس گسترده انجام شوند. این سامانهها با اتصال عاملهای تخصصی در قالب شبکهای پویا موجب میشوند فرایندهای پیچیده مانند مدیریت زنجیره تأمین، نظارت صنعتی، تصمیمگیری مالی یا طراحی مهندسی به صورت مرحلهای و هوشمندانه پیش برود و هر عامل سهم مشخصی در تحقق هدف نهایی بر عهده گیرد.
مدلهای زبانی تخصصی که پنجمین روند این محور را تشکیل میدهند با تمرکز بر صنایع خاص، دقت پردازش و ظرفیت انطباق مقرراتی را افزایش میدهند. بر اساس برآورد صورت گرفته از سوی کارشناسان گارتنر، برخورداری از واژگان تخصصی، ساختارهای معنایی حوزهمحور و دانش صنعتی انباشته امکان میدهد که این مدلها در حوزههایی مانند سلامت، مالی، انرژی یا تولید صنعتی عملکرد قابل اتکایی داشته باشند و خطای تصمیمگیری کاهش یابد. این رویکرد همچنین موجب میشود سازمانها بتوانند برای فعالیتهای حساس و مقرراتمحور از مدلهایی بهرهبرداری کنند که با زمینه صنعتی آنها سازگار است و خروجی قابل اعتماد تولید میکند.
در ادامه، روند ششم یعنی هوش مصنوعی فیزیکی حلقه اتصال جهان دیجیتال و محیط واقعی به شمار میرود و با انتقال قابلیتهای استدلالی و تحلیلی مدلها به روباتها، پهپادها و تجهیزات هوشمند، ظرفیت تازهای برای عملیات میدانی ایجاد میکند. این روند امکان میدهد سامانههای فیزیکی نه فقط اجراکننده دستورات بلکه تصمیمگیرنده باشند و بتوانند در محیطهای پویا، مخاطرهآمیز و نیازمند واکنش سریع مانند عملیات صنعتی، امداد، حملونقل هوشمند یا مدیریت انبار عمل کنند و کارایی عملیاتی سازمانها را به صورت قابل توجهی افزایش دهند.
امنیت، اعتماد و ژئوپلیتیک در کانون راهبردهای آینده
محور سوم با عنوان «پیشتاز» به حوزه امنیت، اعتماد و حکمرانی اختصاص دارد. امنیت پیشدستانه به عنوان هفتمین روند راهبردی، الگوی مقابله با تهدیدها را از مدل واکنشی به سمت تحلیلهای پیشدستانه مبتنی بر هوش مصنوعی تغییر میدهد و امکان جلوگیری از حملات پیش از وقوع را فراهم میکند. منشأ دیجیتال نیز هشتمین روند مدنظر گارتنر به شمار میرود و شفافیت درباره خاستگاه داده، نرمافزار و محتوای تولید شده توسط مدلهای مولد را ضروری میکند تا از اعتبار و انطباق محتوای دیجیتال اطمینان حاصل شود.
از سوی دیگر، پلتفرمهای امنیت هوش مصنوعی روند نهم را شکل میدهند و سازمانها را قادر میسازند که ریسکهای مدلهای ثالث، سامانههای سفارشی و فرآیندهای مبتنی بر هوش مصنوعی را در یک چارچوب کنترل واحد مدیریت کنند. در نهایت، روند دهم یعنی ژئوپاتریاسیون پاسخی راهبردی به فشارهای ژئوپلیتیک محسوب میشود و سازمانها را به سمت انتقال بارهای کاری به زیرساختهای ابری بومی یا منطقهای برای افزایش تابآوری، سازگاری مقرراتی و کاهش وابستگی سوق میدهد.
جمعبندی و پیامدهای راهبردی برای سازمانها
ده روند سال ۲۰۲۶ گارتنر تصویری یکپارچه و چندبعدی از آینده فناوری ارائه میکند و روشن میسازد که رقابت در سالهای پیش رو بر پایه یک توانمندی منفرد استوار نخواهد بود؛ بلکه از ترکیب هوشمندانه مجموعهای از قابلیتها حاصل میشود که هر یک نقش مکمل و تقویتکننده در کنار دیگری دارند. در جهان امروز، سازمانها برای حفظ تابآوری در برابر موج فزاینده پیچیدگی باید درک کنند که زیرساختهای هوشمند تنها زمانی ارزشآفرین خواهند بود که به سامانههای چندعاملی متصل شوند و این سامانهها نیز بدون امنیت پیشدستانه و حکمرانی داده نمیتوانند پایداری لازم برای فعالیت در مقیاس بزرگ را فراهم کنند.
این روندها در کنار یکدیگر معماری جامعی ایجاد میکنند که از توان محاسباتی ابررایانشی تا مدیریت چرخه عمر مدلها، از اعتبارسنجی منشأ داده تا کنترل ریسکهای ژئوپلیتیک و از توسعه سریع نرمافزار تا استقرار هوش مصنوعی در محیطهای عملیاتی را شامل میشود.
در نهایت، میتوان نتیجه گرفت سازمانهایی که از امروز این روندها را در برنامهریزی راهبردی خود بگنجانند و میان آنها پیوند ساختاری برقرار کنند، توانایی بیشتری برای انطباق با محیطهای متغیر، بهرهگیری مسئولانه و امن از هوش مصنوعی و هدایت تحول دیجیتال در مسیر اهداف کلان خود خواهند داشت و میتوانند در سالهای پیش رو جایگاهی رقابتی، پایدار و مبتنی بر نوآوری مستمر به دست آورند.